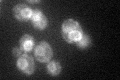
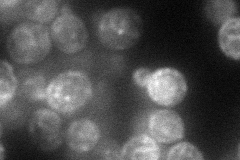
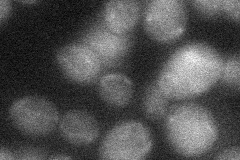
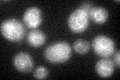
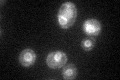

View description
Protein of unknown function, green fluorescent protein (GFP)-fusion protein localizes to the endoplasmic reticulum; msc7 mutants are defective in directing meiotic recombination events to homologous chromatids
Localization:
Intensity:
Fold change:
Significance:
-
C’ GFP library in SD
ER40.75 -
N' NOP1pr-GFP in SD

ER,punctate,bud neck61.2688 -
N' TEF2pr-mCherry in SD
ER,punctate47.2983 -
N' NATIVEpr-GFP in SD

below threshold16.0414 -
N' TEF2pr-VC and Cyto-VN in SD
below threshold21.9594 -
C’ GFP library in SD+DTT
ER37.180.91No -
C’ GFP library in SD+H2O2

ER41.151No -
C’ GFP library in Starvation Media
ER62.261.52Yes -
C’ GFP library on the background of Pup2-DaMP

ER -
C’ GFP library on the background of CCT mutant

ER34.18840.838867No
